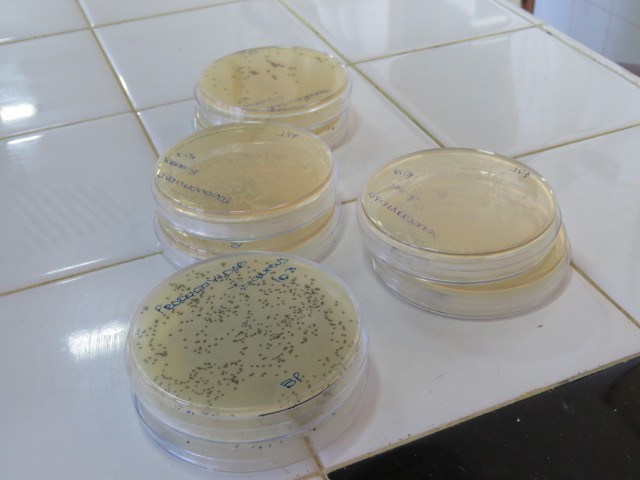
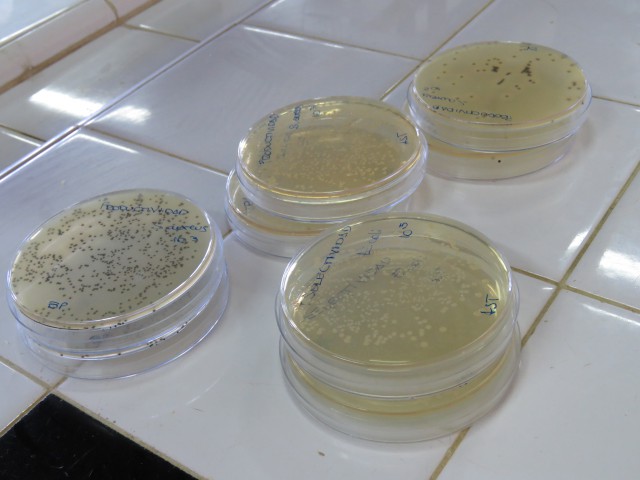
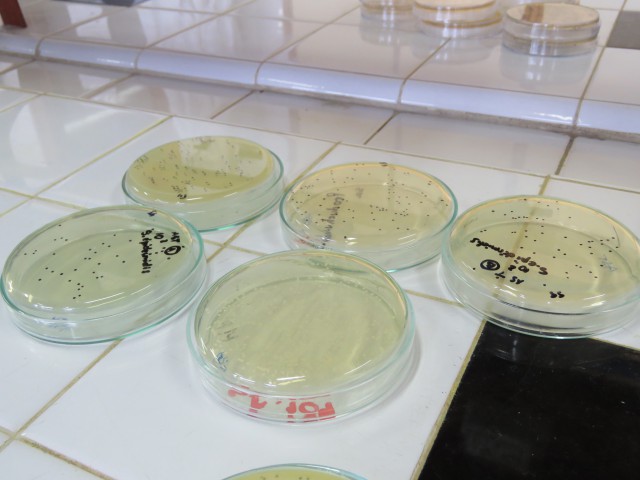
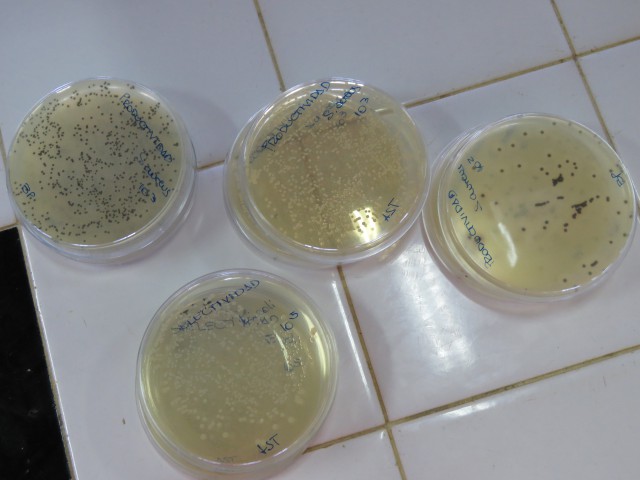

Durante tres días de jornadas completas el equipo de especialistas del Laboratorio de la Cátedra de Microbiología General de la Facultad de Bioquímica y Ciencias Biológicas (FBCB) a cargo de Cristina Lurá, brindó un curso teórico-práctico sobre pruebas de Promoción de Crecimiento de Medios de Cultivo y Preservación, y Conservación de Microorganismos. Las docentes responsables de la capacitación para las Pruebas de Promoción del Crecimiento fueron María Celia Vaccari y María Fernanda Argarañá; mientras que para la Preservación y Conservación de los microorganismos, estuvieron a cargo Marina Rico, Romina Joris y María Inés Pidhirnyj.
Los objetivos que se plantearon las docentes de la FBCB fueron concretos y respondieron a las necesidades planteadas por la delegación de LAFORMED como, por ejemplo, resaltar la importancia del buen manejo y uso de los microorganismos a nivel industrial e investigativo, verificación de la calidad de los medios de cultivo empleados y los diferentes métodos utilizados en la actualidad para el mantenimiento y preservación de microorganismos a largo y corto plazo. También se profundizó en la reactivación de cepas conservadas por diferentes métodos y en la evaluación de la viabilidad de las cepas reactivadas mediante técnicas de recuento.
Mariana Dubois, ingeniera química responsable del área de Control de medicamentos de LAFORMED explicó “Solicitamos este curso para poder fortalecer conocimientos con el fin de cumplir la normativa que regula la industria farmacéutica en lo referente al manejo, control de cepas y promoción de crecimiento de medios de cultivo. Fueron tres días intensos con temas muy abarcativos pero nos vamos satisfechas de los conocimientos adquiridos y agradecidas por el ambiente cordial en que se desarrollaron las actividades”.
Por su parte, Patricia Alegre, bioquímica y parte del equipo dijo “el área de Microbiología es muy interesante y venir aquí fue muy beneficioso para nuestra formación, necesitábamos mejorar nuestras técnicas y encontramos en los docentes de la FBCB excelencia académica y una amplia experiencia en el tema”, finalizó.
Laboratorios LAFORMED SA
Es un laboratorio provincial ubicado en el Parque Industrial de Formosa Capital, dedicado a la producción de medicamentos básicos y de uso frecuente en el tratamiento de las enfermedades más comunes. Los medicamentos producidos cuentan con controles y supervisión de Universidades y Entes Nacionales que garantizan la más alta calidad final del producto.
Desde su inauguración en 2002, este laboratorio ha producido diversos medicamentos para el tratamiento de las enfermedades prevalentes. Su cobertura abarca las salas de Primeros Auxilios, Centros de Salud, Botiquines Parroquiales de CARITAS y responde a demandas extraordinarias en epidemias de la provincia y zona de influencia.
Además produce medicamentos para asegurar la provisión de remedios a costos accesibles a la población. Esta Política es coincidente con la del Estado Nacional y se articula perfectamente con la Ley Nacional de Genéricos y con el Plan Remediar.
Vinculación entre FBCB y LAFORMED
Desde el año 2002 mantiene un convenio con la Universidad Nacional del Litoral mediante el cual el Laboratorio de Control de Calidad de Medicamentos (FBCB), a cargo de Mercedes De Zan, realiza controles de calidad de materias primas, productos intermedios y preparaciones elaboradas por la misma.
En los últimos años la empresa solicitó al Laboratorio el desarrollo, optimización y validación de distintas metodologías analíticas aplicadas al control de calidad de sus productos, con el fin de cumplir con las exigencias regulatorias vigentes de la Administración Nacional de Medicamentos, Alimentos y Tecnología Médica (ANMAT) para la obtención de los certificados que la habilitan a comercializar sus productos fuera del ámbito de la Provincia.
Por otro lado, desde la Cátedra de Microbiología se brindan servicios a terceros de diversa índole y se realizan trabajos de investigación. Es importante destacar que su laboratorio cuenta con un cepario de 350 microorganismos (bacterias, levaduras y hongos filamentosos) conservadas por diferentes métodos, y cuyo desarrollo lleva más de 20 años.